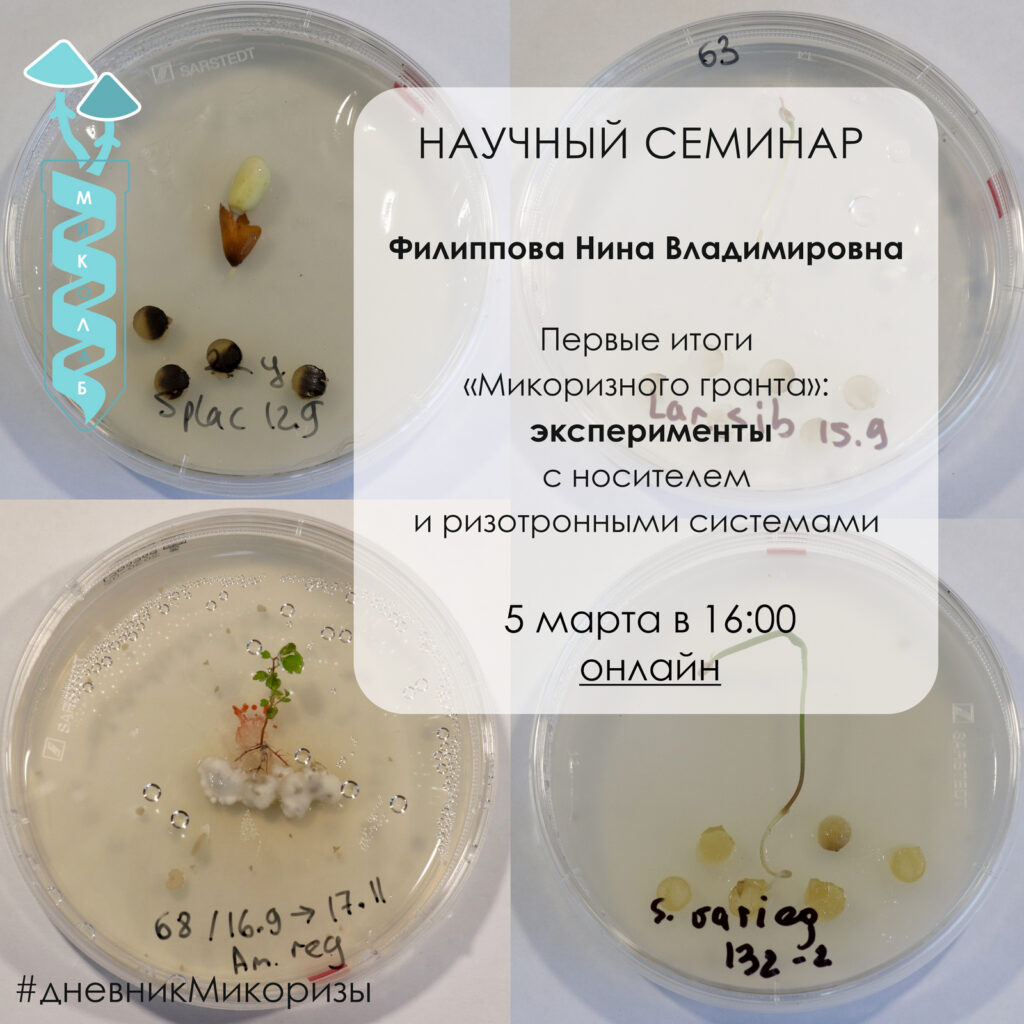

- Тагир Ишманов: Пайплайн для обработки данных метабаркодинга грибов природных сообществ (видео-презентация)
- Нина Филиппова: Публикация исходных данных NGS секвенирования на платформах NCBI, ENA и GBIF (видео-презентация)
- Елена Звягина: Курируемая классификация данных метабаркодинга грибов (видео-презентация часть 1, часть 2)

- Рудыкина Елена: К ревизии рода Dermocybe в коллекции Фунгария ЮГУ (видео-презентация)
- Ишманов Тагир: Метабаркодинг грибов на Illumina и Nanopore. Этапы, инструменты и пайплайны (видео-презентация)
- Филиппова Нина: Инвестиции в открытые данные: набор и статья о данных по паутинникам (видео-презентация)

- Кристина Попеску: Коллекция культур грибов YSU-F: состояние и перспективы развития (видео-презентация)
- Александра Мингалимова: Первые результаты ревизии рода Peltigera фунгария ЮГУ (видео-презентация)
- Нина Филиппова: Стратегия развития коллекции культур YSU-F и успехи культивирования болотных микромицетов (видео-презентация)

- В.А. Дудка — Методы выделения чистых культур эктомикоризных грибов

- Звягина Елена Анатольевна расскажет о результатах анализа видового состава и сообществ одного из самых разнообразных рода Entoloma на 🏔 Приполярном Урале (район Нер-Ойки). Это будет удивительное путешествие в мир красивых грибов, их молекулярных данных секвенирования 🧬🧬 образцов и скрытого разнообразия в субстратах (по данным метабаркодинга).
- Видео-запись семинара (ссылка).

- Cеминар посвящен проекту 🧬 секвенирования самого разнообразного рода 🍄 в наших лесах: Паутинника (Cortinarius). ⏳ Около трех лет ушло у нас на баркодинг основной части коллекции образцов этого рода. Такие данные нужно своевременно оформить в виде базы данных и обеспечить их сохранность. Готовится статья о данных. 🧬 О том, как шла работа по секвенированию, какие ресурсы использовались для хранения данных, инструменты и протоколы обработки сиквенсов, платформы для публикации архивов.
🤪 Паутинник способен запутать, но мы постарались выпутаться. - Видео-запись семинара (ссылка).
- Подробнее о проекте на странице сайта.

Семинар подводит промежуточные итоги микоризного гранта. Первая часть посвящена созданию коллекции штаммов эктомикоризных культур: методам и успешности выделения в поле, таксономической структуре коллекции, мониторингу роста на различных средах, базам данных и экспорту на порталы.
- Видео-запись семинара (часть 1, часть 2).
- Презентация доклада (pdf).
- Подробнее о проекте на странице сайта.
Следующая часть по итогам микоризного гранта: эксперименты с носителем на твердых и жидких средах, создание ризотронных систем.
- Видео-запись презентации (ссылка)
- Презентация (pdf)
- Подробнее о проекте на странице сайта.